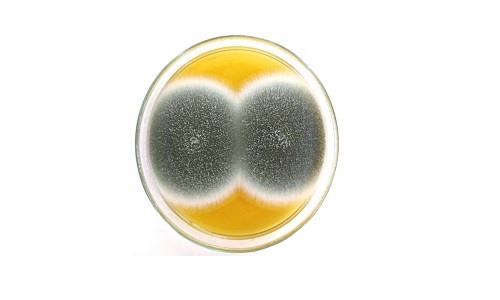

Diario RVL
"Hongo Verde": La otra enfermedad asociada al SARS-CoV-2 que motiva a la preocupación
Primero fue en la India y luego en Uruguay. A nivel mundial son cada vez más los casos notificados de pacientes con COVID-19 que luego de pasar varios días conectados a ventilación mecánica también son afectados por mucormicosis pulmonar, infección poco frecuente pero que agrava la condición de quien la padece, la cual es causada por distintos tipos de mohos del orden mucorales, entre los cuales figura especialmente los Rhizopus u “hongos negros”.
En Chile esta particular enfermedad vinculada al SARS-CoV-2, no es el único foco de preocupación, por que existe otra con características y pronósticos muy similares: la aspergilosis pulmonar asociada a coronavirus o CAPA, originada también por un hongo (el Aspergillus fumigatus) que en este caso es de color verde.
Así lo afirma el director del Centro de Diagnóstico e Investigación de Enfermedades Infecciosas de la Universidad de Valparaíso, Rodrigo Cruz, quien recientemente -junto a especialistas de esa unidad- publicó un estudio que da cuenta de que cinco pacientes con COVID-19 internados en UCI de hospitales de la Región de Valparaíso sufrieron los efectos de este denominado “hongo verde”.
El estudio se acaba de publicar y da cuenta de una investigación clínica realizada entre julio y septiembre de 2020. Desde entonces a la fecha, el CDIEI-UV ha diagnosticados más casos, reportando al menos otros siete.
“Como se trata de una enfermedad cuya notificación no es obligatoria, se desconoce el número exacto de casos. Pero hasta ahora se han reportado solo lo que indica nuestro estudio. Sin embargo, antes de la pandemia en nuestro país se describían esporádicamente algunos casos de mucormicosis y de aspergilosis pulmonar, porque se trata de infecciones provocadas por hongos invasores ubicuos, es decir, que se encuentran en todas partes”, precisa el doctor Cruz.
Según explica el médico infectólogo de la Universidad de Valparaíso, ambas enfermedades tienen los mismos factores de riesgo y se ven más en paciente diabéticos descompensados, inmunodeprimidos y oncohematológicos.
“En el caso de personas con COVID-19, la infección por ´hongo verde’ se diagnostica a través de cultivos o mediante la detección del antígeno (galactomanano) que libera. Mayoritariamente se da en pulmones y en pacientes que llevan varias semanas conectados a ventilación mecánica y bajo tratamiento de corticoides”, acota el director del CDIEI-UV.
Según advierte el médico infectólogo Rodrigo Cruz, la infección causada por este tipo de hongos es grave en sí y se asocia a una mayor mortalidad, dado que ataca a personas que ya se encuentran graves por alguna otra patología de base.
“La presencia de estos hongos por lo general ensombrece los pronósticos, en especial en casos de pacientes diabéticos descompensados, inmunodeprimidos y oncohematológicos que están con soporte ventilatorio. Afortunadamente, su incidencia es baja. Por lo tanto, la detección de estos hongos negros y verdes no es para alarmarse, pero sí para tener en antecedentes y seguir cuidándose”, concluye el especialista.